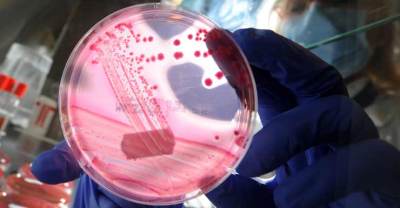

Australian experts are calling for doctors and patients to better distinguish between allergies and side-effects to antibiotic drugs, as new research demonstrates a large proportion of Australians are being incorrectly labeled as allergic to common antibiotics like penicillin.
The research, published in the Medical Journal of Australia on Monday, examined 453 people admitted to the general medicine units of Austin and Alfred hospitals in Melbourne over three weeks last year.
It found 24 per cent of inpatients had an Antibiotic Allergy Label (AAL), when in fact only between 1 and 10 per cent of Australians are actually allergic to Penicillin.
• Scientists search for people with ‘superhero DNA’
• Anti-vaxxers urged to ‘think about community’
• New hope for Australians with severe asthma
Dr Jason Trubiano, co-author and infectious diseases physician at Austin Health and the Peter MacCallum Cancer Centre, told The New Daily that disproportionate conferring of AALs has consequences for both public health and that of the individual.
“Despite advances in medicine, our best antibiotics are still penicillin-based,” Dr Trubiano said. “So when someone is labeled with a penicillin allergy, we can’t give them first-line therapy, we have to give them second- or third-line therapy (different antibiotics).
“These second- and third-line therapies are either less effective or they’ve got significant side-effects. So at a patient level, they’re probably missing out on the antibiotic best suited to treating their condition.
“And on a wider scale, when we use antibiotics that are broader spectrum, we induce antibiotic resistance in these patients when we don’t need to, so there are downstream effects on public health.”
How to tell if you’re allergic
Associate Professor Michaela Lucas, chair of the Australia Society of Clinical Immunology and Allergy’s Drug Allergy Working Party, said it is often hard to tell the difference between an allergy to an antibiotic and a side-effect.
“We know that only 10 per cent of Australians with an antibiotic-allergy label actually have a true life-threatening allergy,”Assoc Prof Lucas said. “The problem is, it is very difficult on history alone to determine who is in this 10 per cent, and the consequences of a doctor saying ‘you are not allergic’ or ‘the chances are you’re not allergic’ could be life-threatening.”
Allergy to antibiotics can be tested for, and Assoc Prof Lucas said the “gold standard” is available from immunology specialists, who expose people to the drug in a safe, monitored setting, to see if the reaction develops.
Click the owl for more on this subject
Dr Trubiano said there were also ways of distinguishing between an allergic reaction and a different adverse reaction (side-effect) without testing.
“If somebody has a history of hives, lip or throat swelling, having recently taken an antibiotic, that is a reaction we would consider allergic, and that person would need further evaluation.
“But symptoms like nausea, diarrhoea or headache are typical side-effects, not indicative of allergies. There are grey areas, but these are key distinctions a person can make.”
Changing thinking around AALs
The study also found AALs were associated with increased prescribing of less common antibiotics. This is significant given, as Dr Trubiano noted, that the more antibiotics infectious bacteria are exposed to, the sooner they start becoming resistant to these antibiotics, ultimately leaving them untreatable and capable of causing serious widespread disease.
Assoc Prof Lucas said people with an AAL still needed to tell their GP they do so that medication can be adjusted accordingly. Moreover, Dr Trubiano said the onus was on medical professionals to decide who needs to be re-evaluated.
“Most of the time if we re-ask that history, patients will report either a drug intolerance, which isn’t an allergy in the first place, or tell you it was 50 years ago and they got a mild rash when they were a child.
“And they are the people that GPs, specialists and surgeons all need to consider re-evaluating.”









